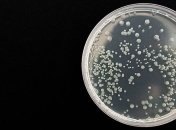
Степень загрязнения воды опасными бактериями теперь легко проверить

Новости по теме Исследование
-

В США представили умный жилет, который поможет ориентироваться в пространстве слабовидящим людям благодаря давления и вибраций.
-

Команда, возглавляемая Британской антарктической службой (BAS), провела исследование, которое поможет лучше изучить китов в отдаленных и недоступных местах.
-

Ученые из Массачусетского технологического института выдвигают новую теорию того, что, возможно, привело планету к каждому ледниковому периоду. И предположили, когда он может повториться.
-

Исследователи из королевского колледжа Лондона проводили обследования людей, которые перенесли коронавирус. Результаты их работы опубликовали на сайте MedRxiv.
-

В Минздраве Японии получили антитела, нейтрализующие коронавирусную инфекцию. Об этом сообщает The Japan Times.
-

Ученые из Университета Рочестера, что в США, создали уникальную алюминиевую панель, которая может очищать воду. Об этом сообщает Nature Sustainability.
-

Исследователи из Эдинбурга создали новую модель расчета землетрясений. Их "творение" использует только математику, без лабораторных исследований.
-

Ученые из США обнаружили естественное вещество, которое запускает механизм уничтожения раковых клеток. Потенциальную терапию рака протестировали на круглых червях и клетках человека в лаборатории.
-

Согласно недавним исследованиям, у тех, кто часто употребляет этот напиток, процент подкожного жира оказался меньше.
-
Болезни, передаваемые через воду, поражают более 2 миллиардов человек во всем мире, что вызывает экономические сложности: на лечение всех этих заболевших требуются ресурсы. Например, в США болезней, передающихся через воду, обходится более чем в $2 млрд долларов в год, ежегодно регистрируется 90 миллионов случаев. На традиционные методы обнаружения бактерий в воде уходит слишком много времени и ученые решили исправить ситуацию. Подробности об их разработке публикует журнал Light: Science & Applications.
-

Изучив фрагмент ровенского янтаря, ученые из России и Украины описали новый вид жуков-скрытноедов времен эоцена, геологического периода, который закончился 39 млн лет назад.
-

Ученые из университета Новой Англии провели новое исследования эволюции мозга и выяснили, что с течением времени его форма не только увеличилась, но и стала "правильной".
-

Ранее считалось, что Луна сформировалась из остатков тела размером с Марс, которое столкнулось с верхней земной корой с незначительным количеством металлов. Но новое исследование предполагает, что поверхность Луны более богата металлом, чем считалось ранее.
-

Первые прямые измерения магнитного поля в хромосфере Солнца были проведены исследовательской группой, включающей физиков из Уорикского университета. Они предоставили первые наблюдательные свидетельства того, что огромные торнадо в атмосфере нашего Солнца возникают в результате закручивания магнитных полей.
-

В первом в своем роде исследовании ученые определили, что генетика может играть роль в заживлении ран. Калеб Филлипс, доцент Техасского технического университета, а также аспирант Крейг Типтон опубликовали результаты своей работы в журнале PLOS Pathogens.
-

Распространение ударных волн в зернистых или гранулированных материалах важно для определения силы землетрясений, определения местоположения нефтяных и газовых резервуаров, проектирования акустической изоляции и разработки материалов для уплотнения порошков. Ученые использовали рентгеновские измерения и анализы, чтобы показать — масштабирование скорости и дисперсия в передаче волны основаны на расположении частиц и цепях сил между ними. Исследование опубликовано в журнале Proceedings of the National Academy of Sciences.


